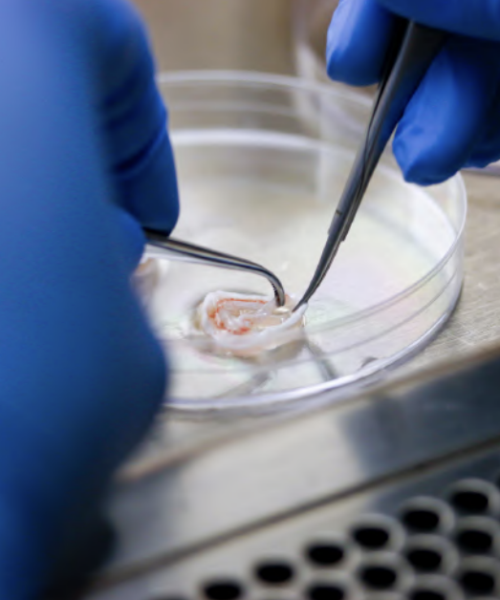

Retina Reporter
The Retina Reporter is our bi-annual Retina Australia newsletter, featuring updates of new medical and scientific research developments. It will also keep you abreast of the activities of Retina Australia and other inherited retinal disease information and stories of interest.
Between each Retina Reporter Newsletter, our e-newsletter, the Retina Insider, will deliver monthly research updates both nationally and internationally and invitations to upcoming webinars and information sessions. These are not acccessible on our website but you can subscribe to our all newsletters here.

Winter Edition 2026
The Winter 2026 edition provides the latest updates in inherited retinal disease (IRD) research, including reports from our 2025 Retina Australia Research Grant recipients, a look back at the progress made in IRD research over the past decade, and current opportunities to participate in research through our IRD Research Project and Clinical Trial Register. You’ll also hear from our CEO and learn why supporting research remains critical through our 2026 Annual Appeal. Together, these stories highlight the progress being made towards a world without inherited blindness.

Summer 2025/2026 edition
In this issue: Message from the CEO; Strategic Plan 2026-2028; Message from the Chair; Retina Australia Awards; Research Grant Impact Report
2026 Research Grants; World Geographic Atrophy Day; Research Project and Clinical Trial Register

Winter 2025
In this issue: Message from the CEO; Research into Inherited Retinal Disease matters – 2025 Annual Appeal; Retina Australia Research Grant Impact Report; Research Grant Impact Highlight; In Focus: From Lab to Life – The path to new medicines and How patients can participate and have their say; Research Update: Recent developments from ARVO; Research Project and Clinical Trial Register – Summary of projects open for participation

Summer 2024/2025 edition
In this issue: Message from the CEO; Scientific and Medical Advisory Committee; 2025 Research Grants; 2024 Christmas Appeal; World Geographic Atrophy Day; In Focus: Inherited retinal disease; Diagnosis and testing; Are there treatments available?; Research participation; Research Project and Clinical Trial Register

June 2024 edition
In this issue: Research Project and Clinical Trial Register; Message from the CEO; Research Update Event; 2024 Annual Appeal; Research Grants Program, Research Grant Impact Reports; Research Grant Impact Highlight; In Focus: Geographic Atrophy; Research Insight: Optogenetics win for retinitis pigmentosa after changing primary endpoint; World Sunglasses Day 2024

December 2023 edition
In this issue: Celebrating 40 years; CEO’s report; 2023 Christmas Appeal; Research Grant Impact Highlight; 2024 Research Grants; In Focus: Stargardt Disease; In Focus: Achromatopsia; Friends of Retina Australia Perth; Retina Australia Christmas office hours

June 2023 edition
In this issue: New website launched, Message from the CEO, Research Grants Program, 2023 Annual Appeal, Retina Australia Research Grants Impact Reports, Webinar 1 Summary – “Bionic Eye” and Updates on Clinical Studies for IRD, Invitation to Webinar 2, Our 40 year Anniversary, Retina Australia membership

December 2022 edition
In this issue: Welcome to Retina Reporter, Report from the Chair, Chief Executive Officer Introduction, 2023 Retina Australia Research Grants, Retina Australia Research Grant Impact Reports, The Role of Genetic Testing and Future Treatments for Inherited Retinal Disease, Friends of Retina Australia